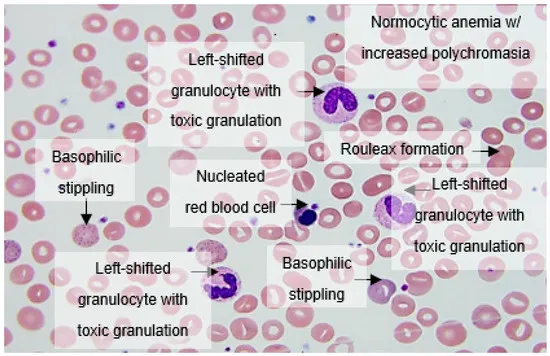
image

EOS - The First 72 Hours
- Onset: Birth to <72 hours.
- Workup:
- Screening: CBC (I/T ratio >0.2), CRP (>10 mg/L).
- Definitive: Blood Culture.
- Empirical Antibiotics:
- Ampicillin + Gentamicin.
⭐ In India, the most common organisms causing EOS are E. coli and Klebsiella pneumoniae, unlike the West where Group B Streptococcus dominates.

The Usual Suspects - Bugs & Risks
- Common Pathogens: 📌 GEL
- Group B Streptococcus (GBS): Most common overall.
- E. coli: Most common in preterms.
- Listeria monocytogenes & Klebsiella.
- Maternal Risk Factors:
- Prolonged Rupture of Membranes (PROM) > 18 hrs.
- Preterm delivery < 37 weeks.
- Intra-amniotic infection (chorioamnionitis).
- Maternal GBS colonization.
- Intrapartum fever > 38°C.
⭐ E. coli is the leading cause of early-onset sepsis and meningitis in preterm neonates.

Spotting Sepsis - Subtle Signs
- Systemic: Temperature instability (hypothermia <36.5°C or fever >38°C), lethargy, poor cry, hypotonia.
- Cardio-Respiratory:
- Tachypnea (>60/min), grunting, retractions, apnea.
- Tachycardia (>160/min) or bradycardia (<100/min).
- Poor perfusion: ↑Capillary refill time >3s, mottling, cool peripheries.
- GI/CNS: Refusal to feed, vomiting, abdominal distension, jaundice, seizures, bulging fontanelle.
⭐ The triad of respiratory distress, temperature instability, and feeding difficulty is highly suggestive of neonatal sepsis.

The Sepsis Workup - Lab Lockdown
-
Gold Standard: Blood culture is definitive. Collect >1 mL before starting antibiotics.
-
Sepsis Screen (Töllner's Score): A combination of tests to guide empirical therapy.
- Hematology:
- TLC: <5000/mm³ (leukopenia) is a strong predictor.
- Absolute Neutrophil Count (ANC): See reference charts for age.
- Immature/Total (I/T) Neutrophil Ratio: >0.2 is highly suggestive.
- Acute Phase Reactants:
- C-Reactive Protein (CRP): >10 mg/L. Serial measurements (24-48h) are more valuable. ↑ levels indicate infection.
- Micro-ESR: >15 mm in the first hour.
- Hematology:
-
Lumbar Puncture (CSF analysis): Mandatory for all neonates with suspected sepsis.
-
Chest X-ray: Indicated if respiratory signs are present.
⭐ A negative sepsis screen (especially CRP and I/T ratio) at 24-48 hours has a high negative predictive value, allowing for safe discontinuation of antibiotics if blood culture is also negative.
Antibiotic Arsenal - Treatment Tactics
- Empiric Therapy: Initiate immediately after cultures.
- First Line: Ampicillin + Gentamicin
- Covers GBS, E. coli, Listeria.
- Suspected Meningitis: Ampicillin + Cefotaxime
- Gentamicin has poor CSF penetration.
⭐ Exam Favourite: Cefotaxime is preferred over Ceftriaxone in neonates. Ceftriaxone displaces bilirubin from albumin, increasing the risk of kernicterus, and can cause biliary sludging.
Duration of Therapy
- Bloodstream infection: 10-14 days
- Meningitis: 14-21 days
High-Yield Points - ⚡ Biggest Takeaways
- The most common cause of early-onset sepsis is Group B Streptococcus (GBS), acquired vertically.
- Onset occurs within the first 72 hours of life, distinguishing it from late-onset sepsis.
- Key risk factors: maternal GBS colonization, preterm delivery, and prolonged rupture of membranes (>18h).
- Respiratory distress is the most frequent clinical sign; presentation is often subtle.
- Blood culture remains the gold standard for diagnosis.
- First-line empiric therapy is IV Ampicillin and Gentamicin.
Unlock the full lesson and continue reading
Signup to continue reading this lesson and unlimited access questions, flashcards, AI notes, and more